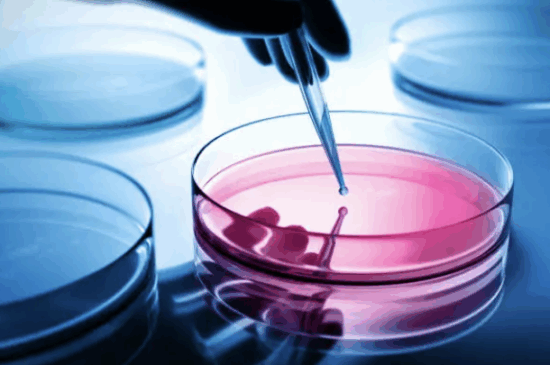

We drive our customer’s development projects
Explore our comprehensive suite of services tailored to advance novel biotherapeutics at every stage.
Download our Service Guide here


Explore our comprehensive suite of services tailored to advance novel biotherapeutics at every stage.
Download our Service Guide here

CMC roadmaps and
development plans
Quality by design
support
Vector design

Upstream,
downstream and end-
to-end processes
Process optimization
Process
characterization
Cell line development
and optimization

Analytical release and characterization plans
Particle
characterization
Impurity profiles
Process Analytical Technology tools

Pre-established GMP Alliances
Seamless
technology transfer
Manufacturing
oversight

Experience expertise in strategy development tailored to optimize efficiency, minimize risks, and maximize the outcome of your process development projects.
Experience expertise in strategy development tailored to optimize efficiency, minimize risks, and maximize the outcome of your process development projects.
A thoroughly crafted CMC strategy is vital to navigate your projects through the various development stages without losing sight of the important elements.
In our assessments, we not only provide a tailored process development plan but also evaluate sourcing of adequate starting materials, include analytical, formulation, stability aspects and account for regulatory and quality compliance. With our CMC roadmaps, we significantly elevate your chances of success, guiding you seamlessly from conception to market launch.
We are committed to Quality by Design (QbD) principles, fostering comprehensive process understanding, regulatory compliance, and exceptional product quality. We support implementation of these principles, definition of (quality) target product profiles, and identification of critical quality attributes as well as associated process parameters. Ultimately, we translate our findings into a phase appropriate process control strategy.

Specializing in phase-appropriate process development, we offer expertise across a spectrum of vital areas. With a commitment to deep process understanding, we strike the perfect balance between quality, cost, and speed, empowering you to navigate your projects with confidence.
Specializing in phase-appropriate process development, we offer expertise across a spectrum of vital areas. With a commitment to deep process understanding, we strike the perfect balance between quality, cost, and speed, empowering you to navigate your projects with confidence.
From defining individual unit operations to developing complete upstream, downstream, or end-to-end manufacturing processes, our focus remains on enhancing process efficiency while ensuring scalability and robustness. We develop a streamlined process to bring your product candidate to clinical proof-of concept and beyond.
By refining and optimizing your existing manufacturing procedures we deliver scalable and robust processes primed for commercial success.
Establishing tailored scale-down models, we support process characterization activities of your late-stage development project, providing valuable insights for process performance qualification (PPQ).
Therapeutic proteins and antibodies:
Viral systems:

Elevate your biotech endeavors with bespoke process analytics designed and established to optimize your biotherapeutics development.
Elevate your biotech endeavors with bespoke process analytics designed and established to optimize your biotherapeutics development.
By employing advanced biological and biochemical assays, we precisely measure product titers and analyze product impurities to refine production processes to perfection.
Using state-of-the-art biophysical methodologies, we characterize viral particles, including particle size distribution and aggregation status. For AAV-specific projects we are able to distinguish between full and empty particles and assess optimal transgene delivery.
Harnessing cutting-edge Process Analytical Technology (PAT) tools, we enable real-time monitoring and fine-tuning of every production aspect, enhancing both efficiency and quality control.
Ultimately, our comprehensive range of analytical services includes strategic planning for product release and characterization, ensuring adherence to regulatory standards and quality benchmarks.

Benefit from a smooth transition from process development to GMP manufacturing, ensuring continuity and efficiency throughout.
Benefit from a smooth transition from process development to GMP manufacturing, ensuring continuity and efficiency throughout.
Leveraging our established GMP Alliances, we navigate GMP manufacturing, empowering your biotech ventures to flourish. We guide CMO selection, facilitating informed decisions and choosing optimal partnerships for your project‘s success.
With meticulous attention to detail, we oversee technology transfer ensuring a seamless and effective transition to GMP production.
Through comprehensive manufacturing oversight, we ensure the preservation of quality and integrity at every project stage.

